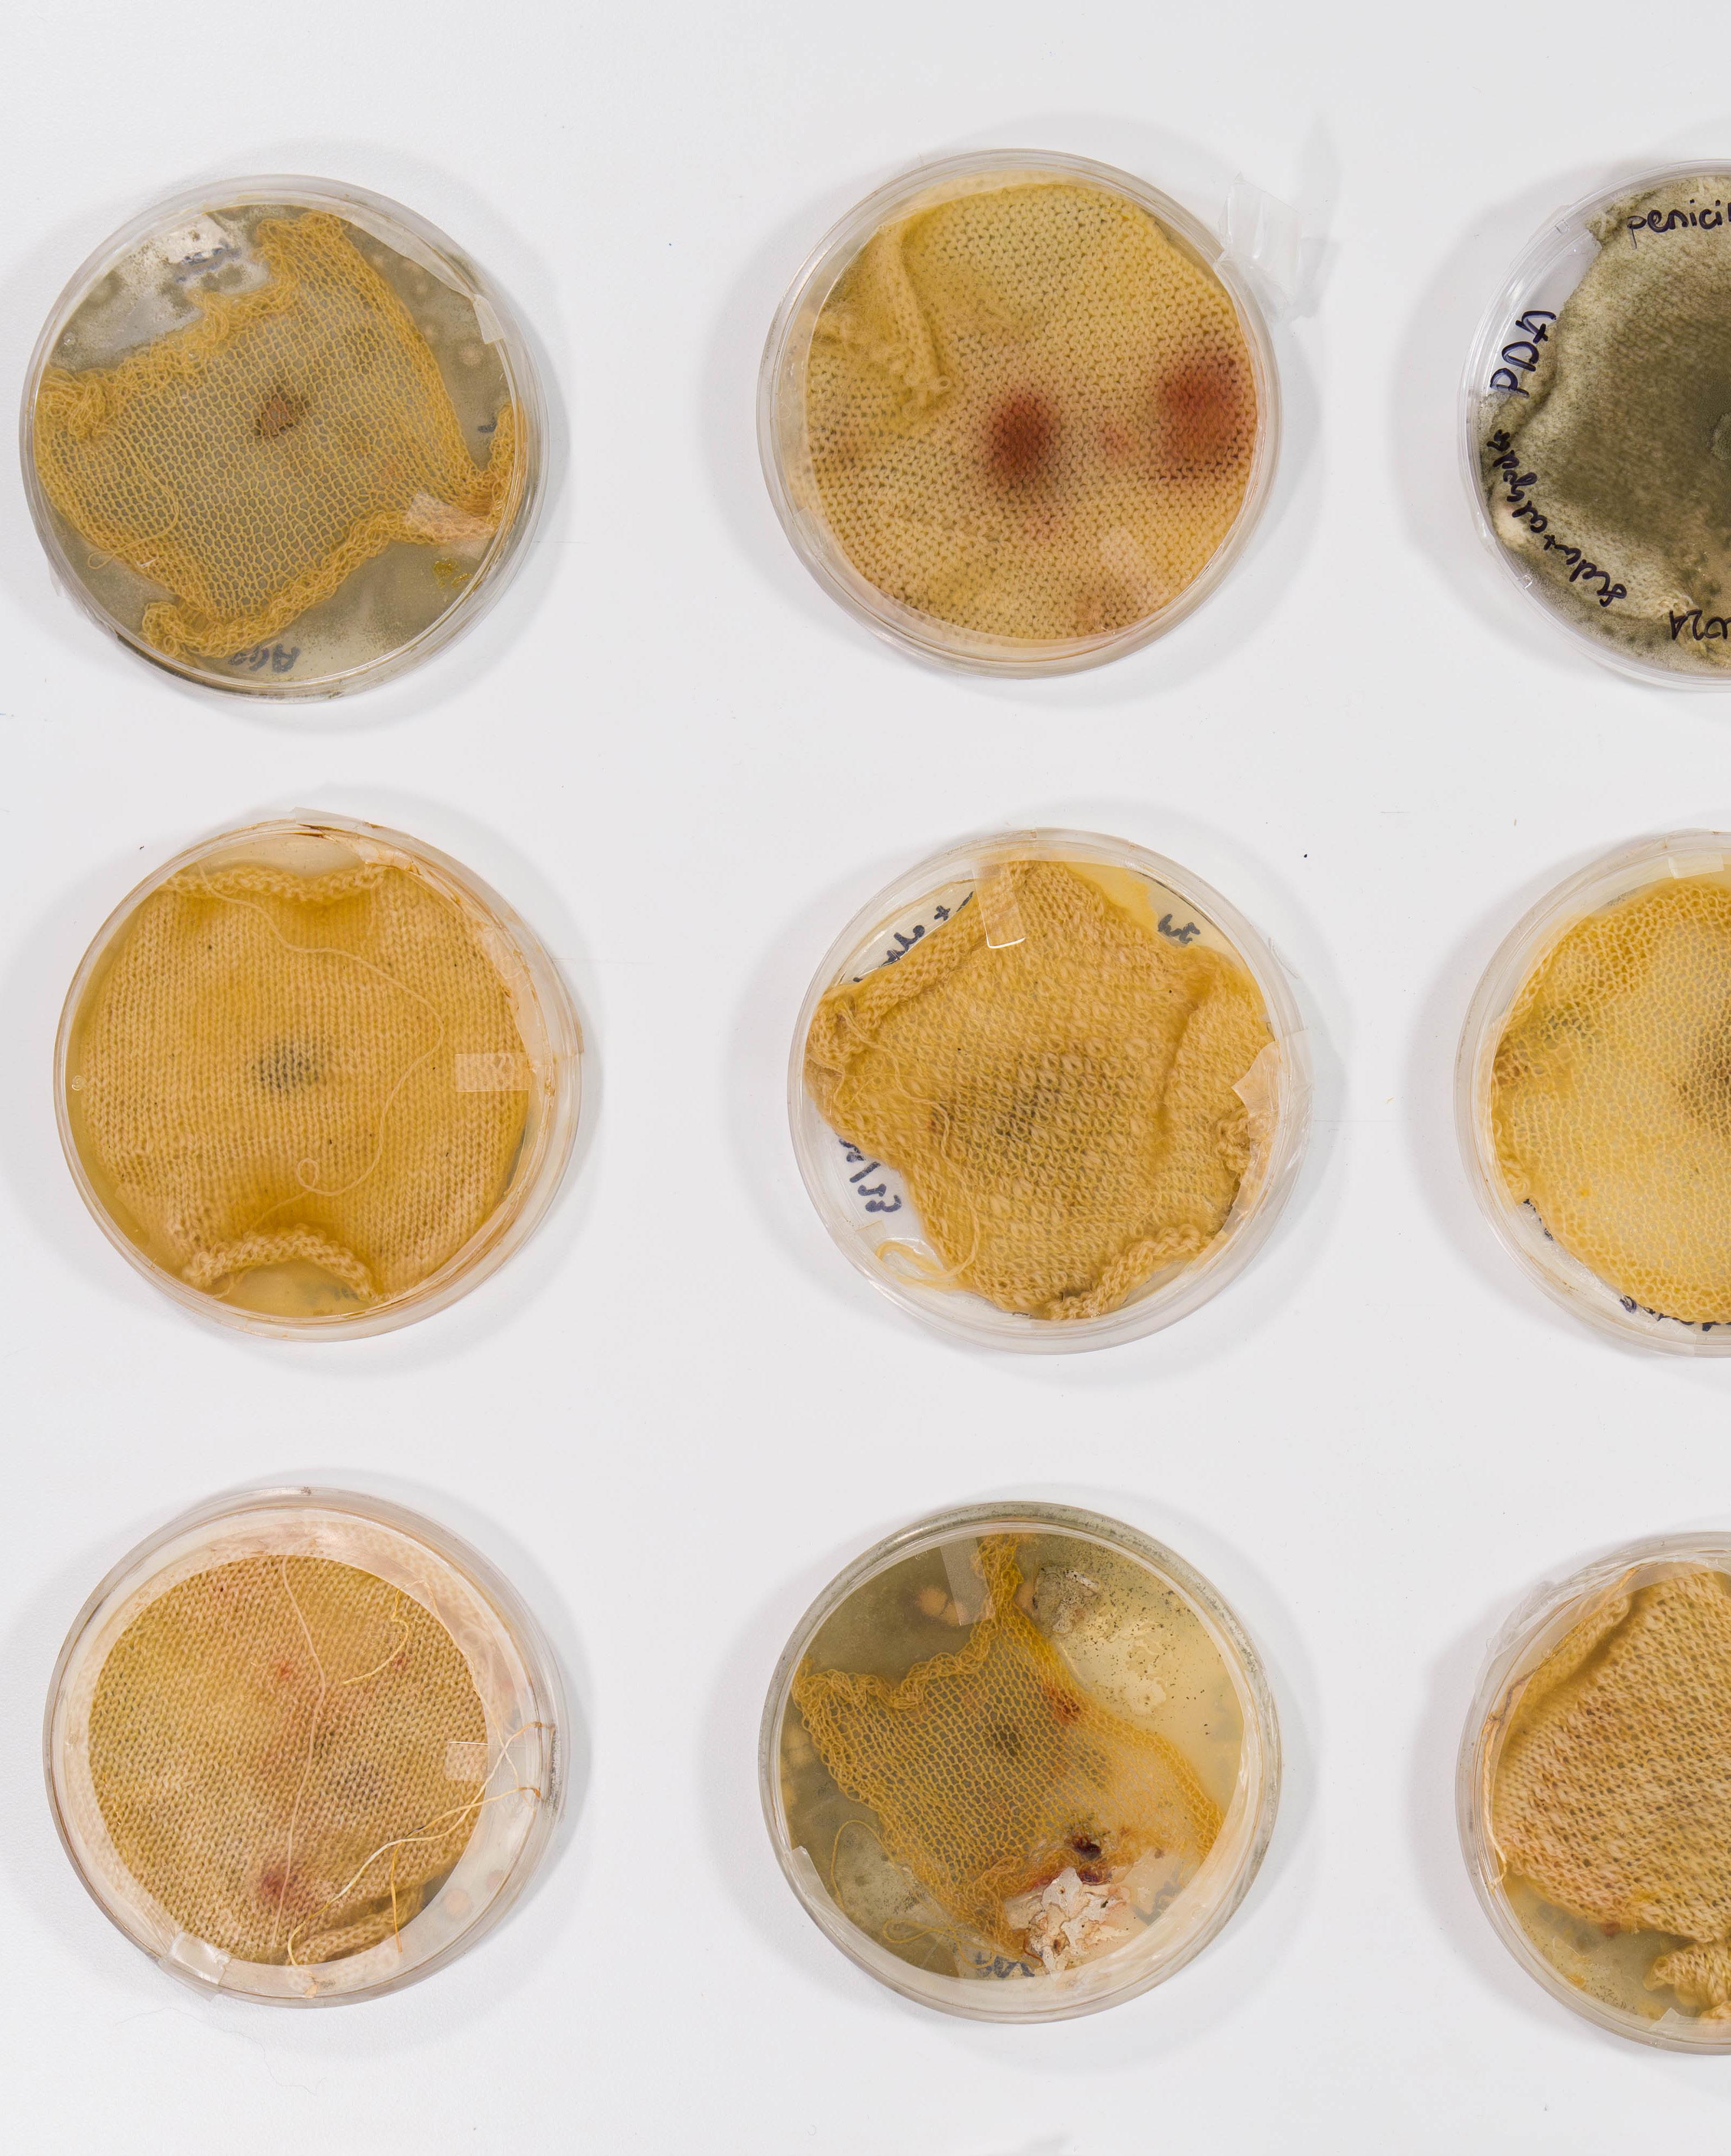
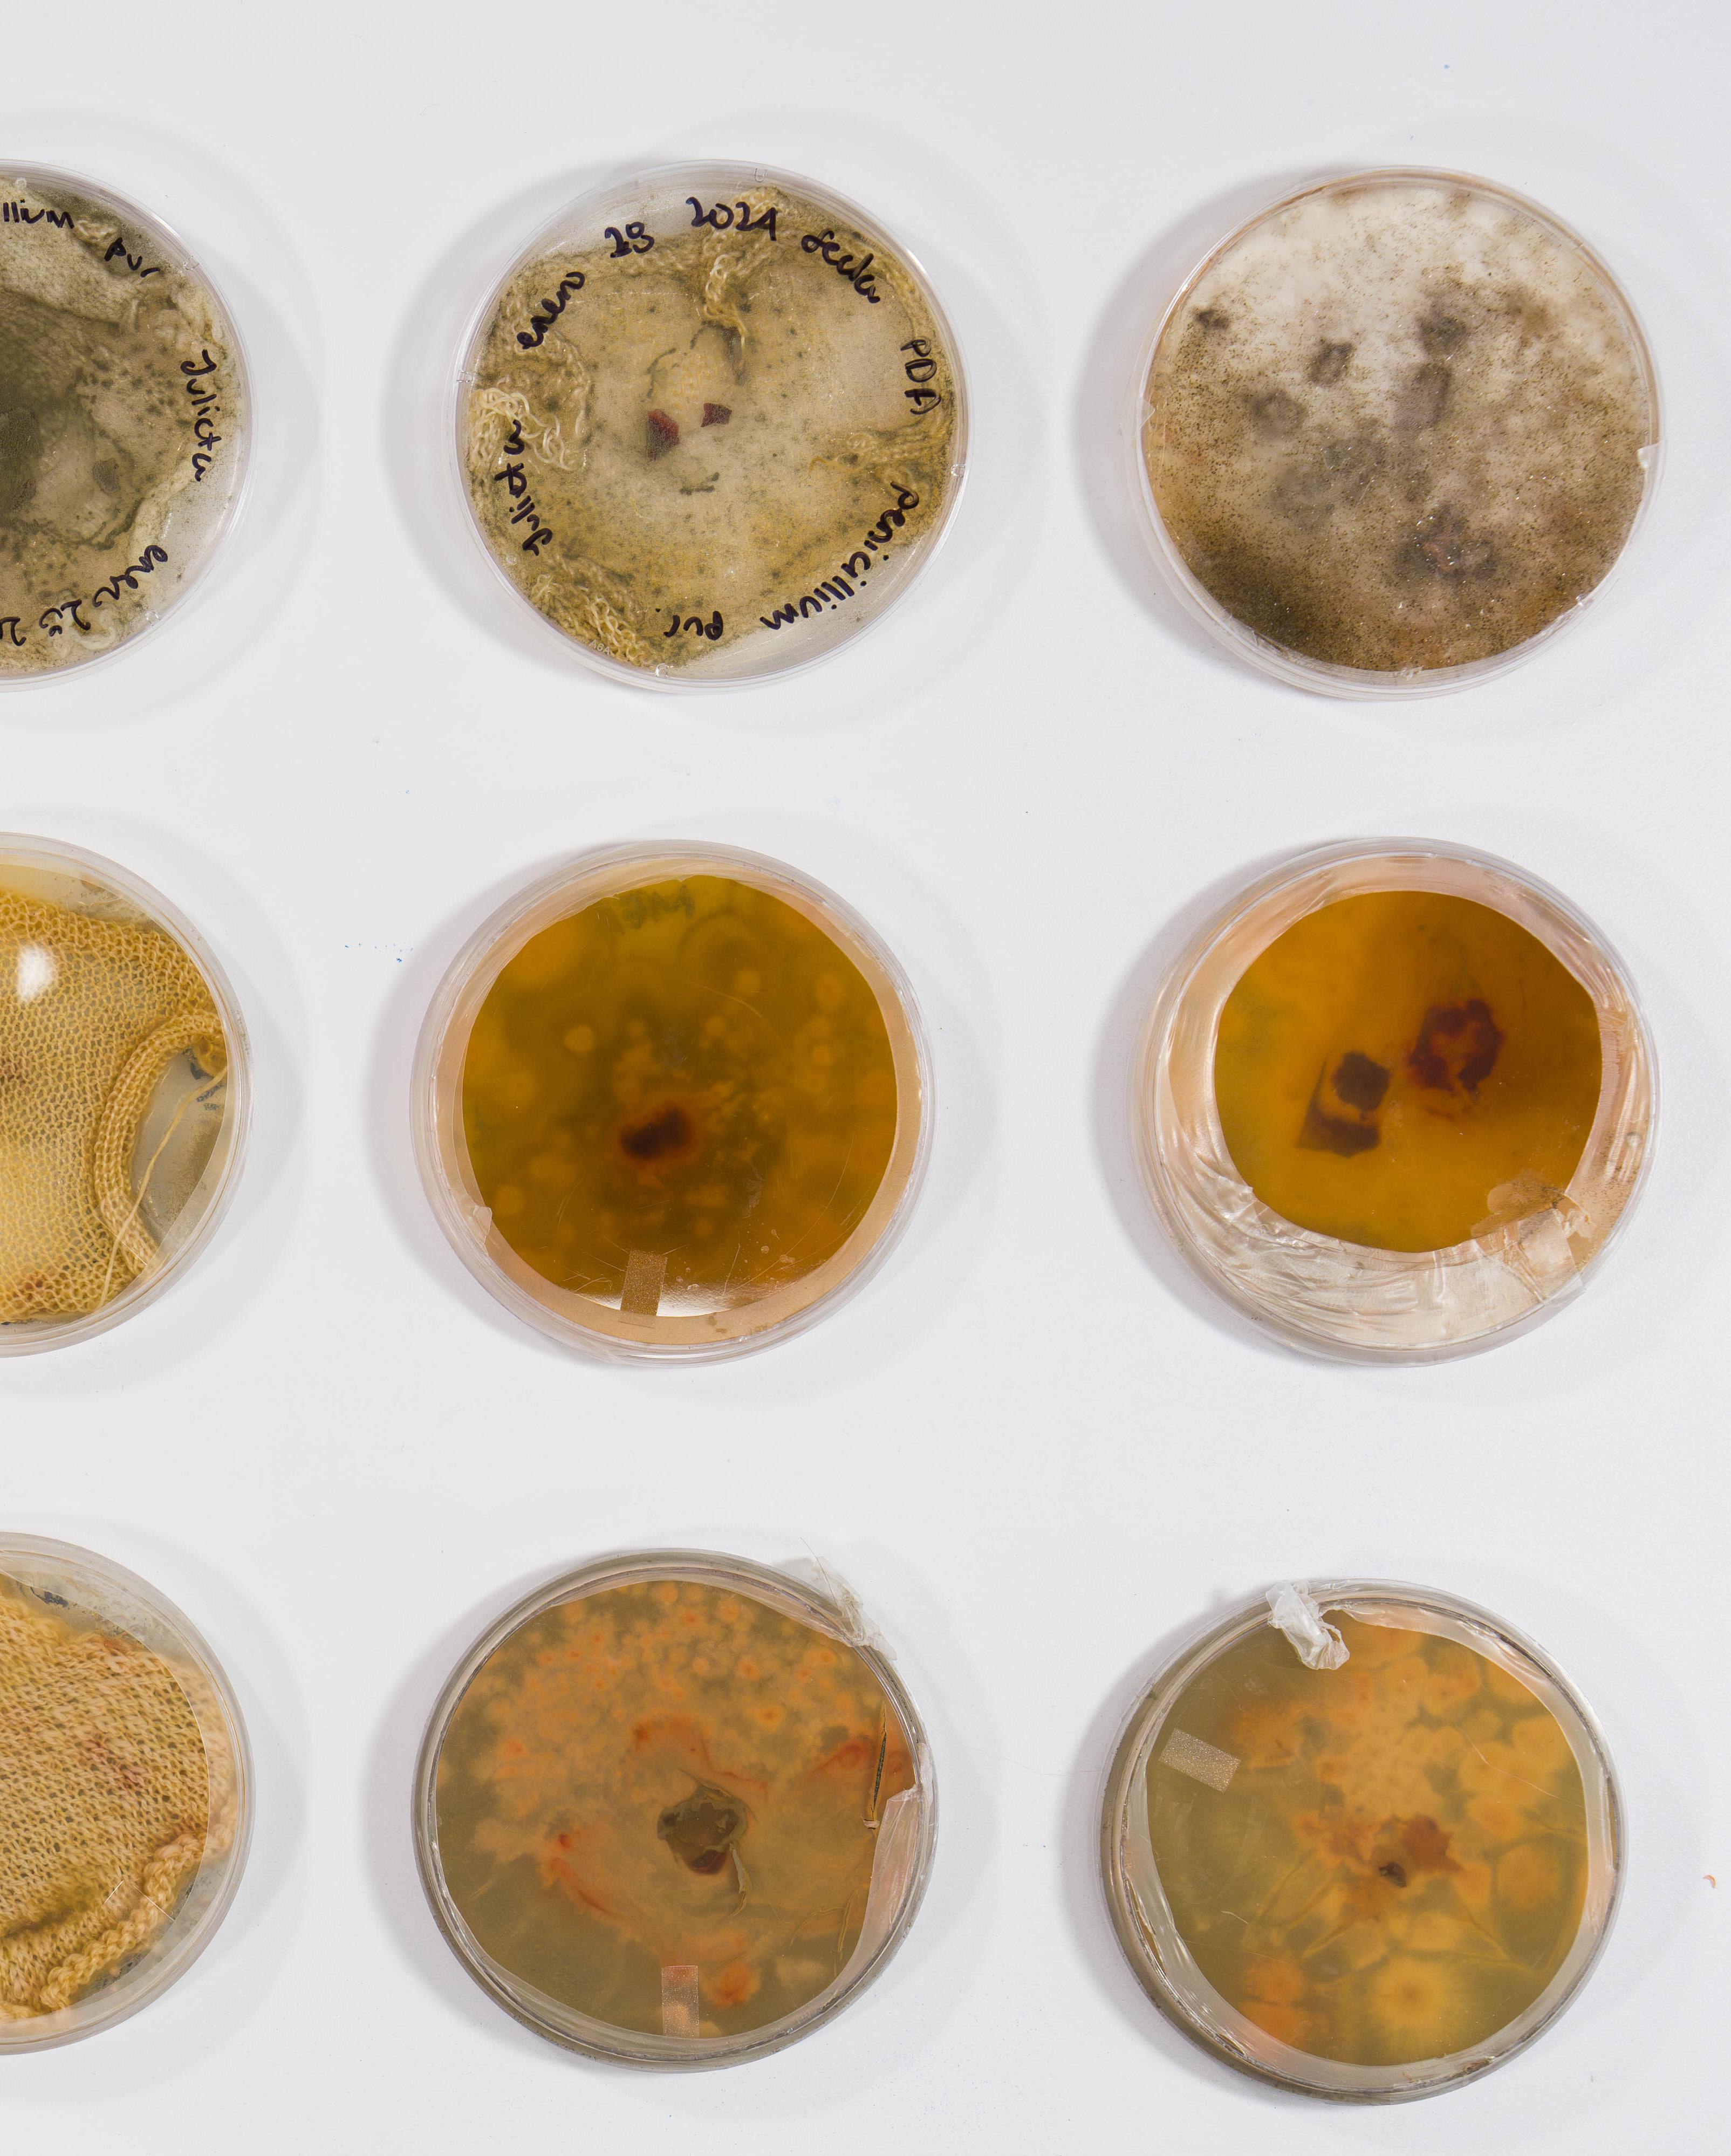
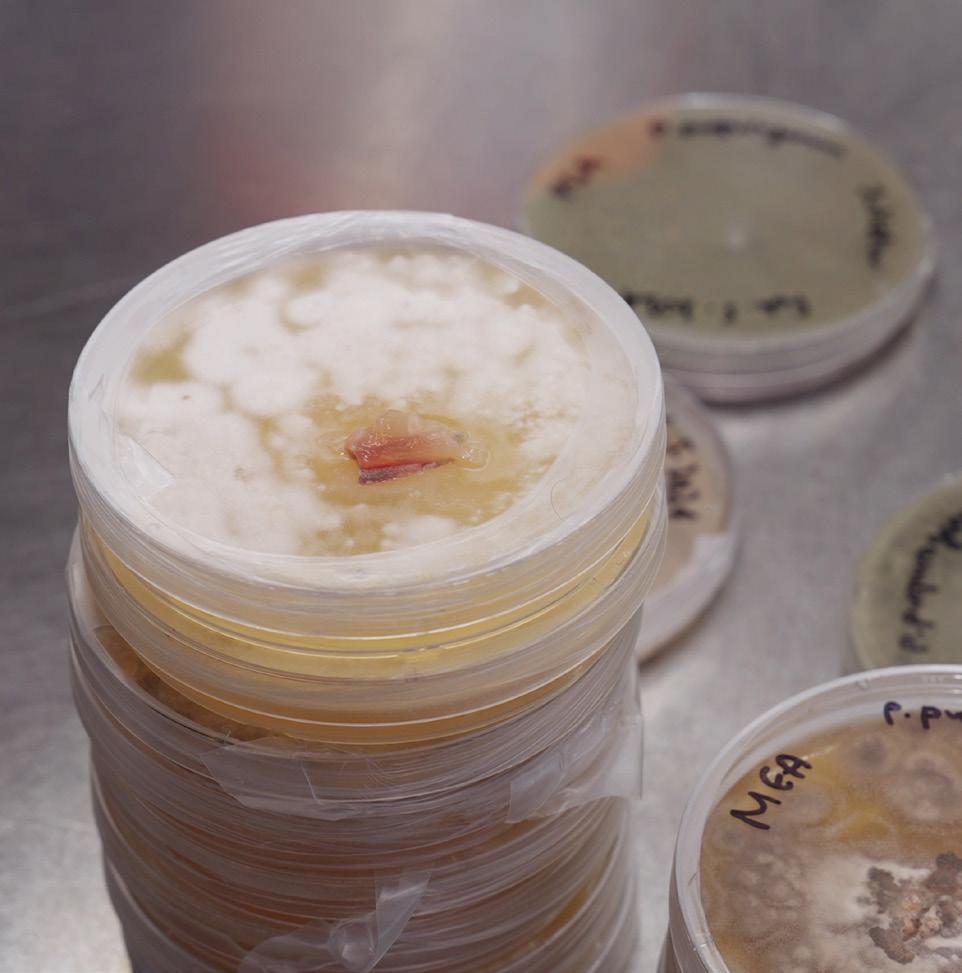

Nature’s Fantasia







As a creator, I navigate through nature, experimentation, and sustainability. Drawing inspiration from the intricate beauty of nature, I am often captivated by the subtle details and hidden complexities of the world we inhabit. Whether it’s the delicate symmetry of a skeleton leaf or the rhythmic patterns found in fungi, I am endlessly fascinated by the interconnectedness of all living things.
In my practice, I strive to translate these observations into tangible forms, employing a variety of mediums and techniques to bring my vision to life. One of my primary mediums is knitting. I use the knitting machine and natural fibers like silk, wool, and cotton to create intricate patterns and textures reminiscent of natural phenomena. For example, I might draw upon the delicate symmetry of a mushroom to inform the intricate lacework of a knitted piece. In addition to knitting, I am deeply intrigued by the potential of biomaterials, such as fungi dye and bioplastics, to revolutionize sustainable practices. By cultivating fungi in controlled environments, I can harness their natural pigment-producing properties to create vibrant, unique prints for my textiles.
Similarly, I explore the possibilities of bioplastics derived from organic sources such as algae and agar, which offer a renewable alternative to conventional plastics. I explore the use of natural dyes sourced from plants, fruits, and flowers. By harnessing the vibrant hues in nature’s palette, I can infuse my work with rich, organic colors that reflect the beauty of the natural world.
I explore the inherent potential of organic processes through experimentation with these materials and techniques. I seek to evoke emotion and provoke thought, challenge preconceived notions, and expand the boundaries of perception. Each piece I create reflects my commitment to ethical practices and mindful consumption.
My work is driven by a profound desire to create moments of connection and resonance, bridging the gap between the viewer and the natural world and fostering a deeper appreciation for the wonders around us. Ultimately, my work celebrates the human experience and pays tribute to the awe-inspiring beauty of our world. My creative work aims to inspire others to see the world with new eyes and embrace its inherent magic and mystery.











I grew up in Bogotá, Colombia, a city of striking contrasts, juxtaposing the modern city and the Andes mountain range. The landscape has the colors of contemporary buildings and colonial roof tiles from the colonial era and the green from the mountains at the east, where farmers cultivate coffee, potato, corn, and other crops.
This duality of city chaos and natural serenity profoundly influenced me, as weekends meant escaping to Facatativa to visit my grandparents
and immerse myself in outdoor activities with my family. Climbing trees with my brother and cousins left a lasting imprint, inspiring me to discover and explore nature as I observed and deepened myself into a magical, unseen world.
Now, I consider myself a nature lover. I’m passionate about the organic textures in nature and the unpredictable beauty of decomposition and decay.





Looking for a way to redefine waste and material utilization, I delved into a bioplastic exploration through sustainable materials and food waste. I explored bioplastics using recipes incorporating Carrageenan Kappa, Potato Starch, Alginate, and Agar combined with fruit
waste, such as blueberries, onion skin, avocado seeds, and orange peels. The resulting swatches revealed a variety of textures and colors, each possessing its unique language, echoing the dialogue of textiles and time.

I delved into investigating the potential of microscopic fungi in a creative context in search of creating environmentally responsible textiles. In this way, I aim to reveal the aesthetic potential of a resource we are prejudiced and consider foreign.
After a long process of experimentation with different types of fungi, nutrient mediums, and fibers (silk, cotton, linen, among others),
I created unique patterns free from polluting elements. It is a new way to design and build without harming our ecosystem, and the results are prints that reflect the delicacy, sensitivity, and transitory beauty of the fungi.

To deepen my connection with nature, I experimented with leaves and flowers, looking for a way to incorporate them into my work. Inspired by the geometry found in the skeleton of leaves, I delved into an exploration of obtaining the leaf’s intricate veins and delicate structure. The leaves were meticulously prepared, delicately removing their outer
skin to reveal their underlying structure. This process required patience and precision, as any damage to the delicate veins of the leaves could compromise their integrity.
I also explore using natural dyes from fruits like blueberries, onion skins, and avocado pits and flowers like hibiscus and pea flowers to harness the vibrant colors in nature’s palette.




I use the knitting machine and natural fibers like silk, wool, and cotton to translate the organic textures and geometric patterns I find in nature. For example, I’ll translate a geometric structure
I see in a mushroom into lace knitting, playing with the thickness of the yarn and the openness and closeness of the knitting.






Nostalgia
Date: 2022-10
Materials: Leaves, silk
Techniques: Knitting machine

Nostalgia is a textile piece symbolizing the delicate nature of memories and their eventual fading. The choice of leaves as a central element in the creation of Nostalgia is deliberate and symbolic. Leaves, with their intricate veins and delicate structure, represent the fleeting
nature of memories. Like memories, leaves are transient, subject to change and decay over time. By stripping away their outer layers to reveal their skeletal framework, I expose the essence of memory—something beautiful yet fragile, enduring yet ephemeral.





Date: 2024-04
Materials: Silk, fungi, Swarovski crystals
Techniques: Knitting machine, fungi dye, embroidery

Wuasi is an exploration into fungi dye that combines sustainable fashion and biodesign. Through Wuasi, I’ve successfully produced dyed fabrics with fungi dye that not only showcase
unexpected and unique designs but also contribute to reducing the fashion industry’s environmental footprint.







Date: 2024-04
Materials: Silk, cotton, wool, flowers, leaves, algae, agar, glycerin
Techniques: Knitting machine, natural dyes, bioplastics

“Nature’s Fantasia” celebrates the intricate beauty of the natural world. Inspired by the multifaceted systems within nature, this project invites viewers to delve into the mesmerizing patterns, textures, and interconnectedness found throughout our ecosystem. From the organic textures of leaves to the geometric designs of seeds and the dynamic networks
of mycelium, each artwork reflects the fragility and importance of preserving biodiversity. By immersing ourselves in the captivating patterns of nature, we are reminded of the delicate balance and symbiotic relationships that sustain life on Earth, fostering a deeper connection and appreciation for the wonders of our planet.















Take a moment to breathe, let the time be empty of minutes let everything pass, let the day find the sun in the window, let the words finally rest and open your senses to observe
Listen to the whispers of nature knitting the intricate symphony of life translating the forgotten whispers of the leaves and the ephemeral dance of fungi
Every petal, every breeze, and every ray of sun contains a story waiting to be told you become an observer, Surrounded by the delicate beauty of organic geometry and the silent poetry of decay
Search for the mysteries of existence, the connecting threads between the tangible and the intangible make the unseen seen
Don’t be afraid to explore with your hand Become an explorer and embrace your sense of curiosity and wonder.


To my parents, Elizabeth and Alberto, thank you for being the sources of inspiration in my life and constantly supporting me in all my projects.
To Sergio, thank you for your jokes and annoyances, which help me release stress when I need it most.
To my friends, thank you for always being there and making this experience unforgettable.
To my mentors, thank you for helping me capture my ideas and bring out the sensitivity within me.
2022 / 2024
Parsons School of Design
MFA Textiles